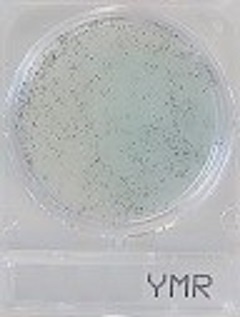

Compact Dry YMR
- Gebrauchsfertige und leicht zu handhabende Platte: Die Vorbereitung des Mediums ist nicht erforderlich, wodurch die Verschwendung von Medium und Vorbereitung des Mediums entfällt.
- Der Nachweis von Kolonien auf der Platte ist einfach und eindeutig.
- Einzelne Kolonien auf der Platte können für weitere Identifizierungstests isoliert werden.
Gebrauchsfertige Petrischalen für die zuverlässige mikrobiologische Analyse auf schnelle Pilze und Hefen
With Compact Dry YMR yeasts and mould can be differentiated by colour development. The medium contains the chromogenic enzyme substrate X-Phos which turns blue with many yeasts. Moulds form fluffy colonies with a characteristic colour. Antibiotics inhibit the growth of bacteria. The Compact Dry YM allows a very good 3-dimension growth of yeast and mould. Compact Dry YM is AOAC submitted
Incubation time and temperature: 48 - 72 h at 25 - 30 °C
Shelf life: 12 months after manufacturing
Storage: Room temperature (+ 1 to + 30 °C)
Sample pretreatment
Viable count in water or liquid foodstuff
Drop 1 ml of specimen (dilute if necessary) on the middle of the Compact Dry plate.
Viable count in solid foodstuff
Add buffer solution to the sample and homogenize by stomacher®. Drop 1 ml of specimen (dilute if necessary) on the middle of the dry sheet of the Compact Dry plate.
Viable count in swab test specimen
Use the swab to wipe the surface, put into the device with wiping solution. Drop 1 ml of wiping solution (dilute if necessary) on the middle of the Compact Dry plate. It is recommended to use “Swab for Compact Dry” offered by HyServe Id-No. 1 002 952/3 (40/240 pieces)
Test instructions
1. Open the cap and drop 1 ml of specimen on the middle of the Compact Dry plate.
2. Specimen diffuses automatically and evenly into the sheet and transforms the dried sheet into a gel within seconds.
3. Put the cap again on the plate and write the information needed on the memorandum section.
4. Turn over the capped plate and put in the incubator.
5. After incubation count the number of colored colonies underneath the plate. White paper placed under the plate helps to count the colonies.